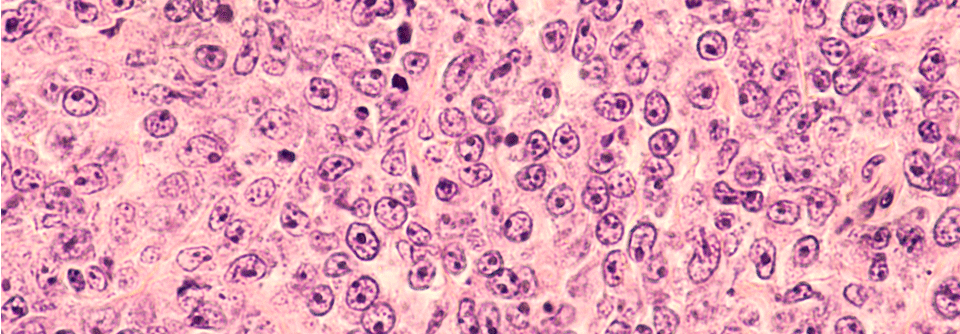

B-Zell-Lymphome: die Qual der Wahl
 An Behandlungsmöglichkeiten mangelt es bei Lymphomen nicht.
© Dr. N. Lange – stock.adobe.com
An Behandlungsmöglichkeiten mangelt es bei Lymphomen nicht.
© Dr. N. Lange – stock.adobe.com
Gentechnologie, Antikörper, Small Molecules oder Immunmodulatoren – neben der klassischen Chemotherapie stehen mittlerweile viele weitere Ansätze für die Behandlung von B-Zell-Neoplasien zur Verfügung. Das eröffnet neue Möglichkeiten, allerdings fehlen häufig noch konkrete Empfehlungen zur Verwendung dieser Präparate.
Diffuses großzelliges B-Zell-Lymphom
Beim diffusen großzelligen B-Zell-Lymphom kommen „die Neuen“ zum Einsatz, wenn die initiale R-CHOP(Rituximab, Cyclophosphamid, Doxorubicin, Vincristin , Predniso(lo)n, Prednisolon)-Immunchemotherapie nicht zur Heilung führt. Vor allem die CAR-T-Zellen haben hier laut Professor Dr. Kami Maddocks von der Ohio State University eine…
Bitte geben Sie Ihren Benutzernamen und Ihr Passwort ein, um sich an der Website anzumelden.
Bereiche
- Allergologie
- Allgemeinmedizin
- Alternativmedizin
- Angiologie
- Chirurgie
- Dermatologie
- Diabetologie
- Endokrinologie
- Gastroenterologie
- Geriatrie
- Gynäkologie
- HNO
- Infektiologie
- Innere Medizin
- Kardiologie
- Naturheilkunde
- Nephrologie
- Neurologie
- Onkologie und Hämatologie
- Ophthalmologie
- Orthopädie
- Pädiatrie
- Palliativmedizin und Schmerzmedizin
- Pneumologie
- Psychiatrie
- Rheumatologie
- Sportmedizin
- Urologie
- Alle Beiträge
- Kongress aktuell